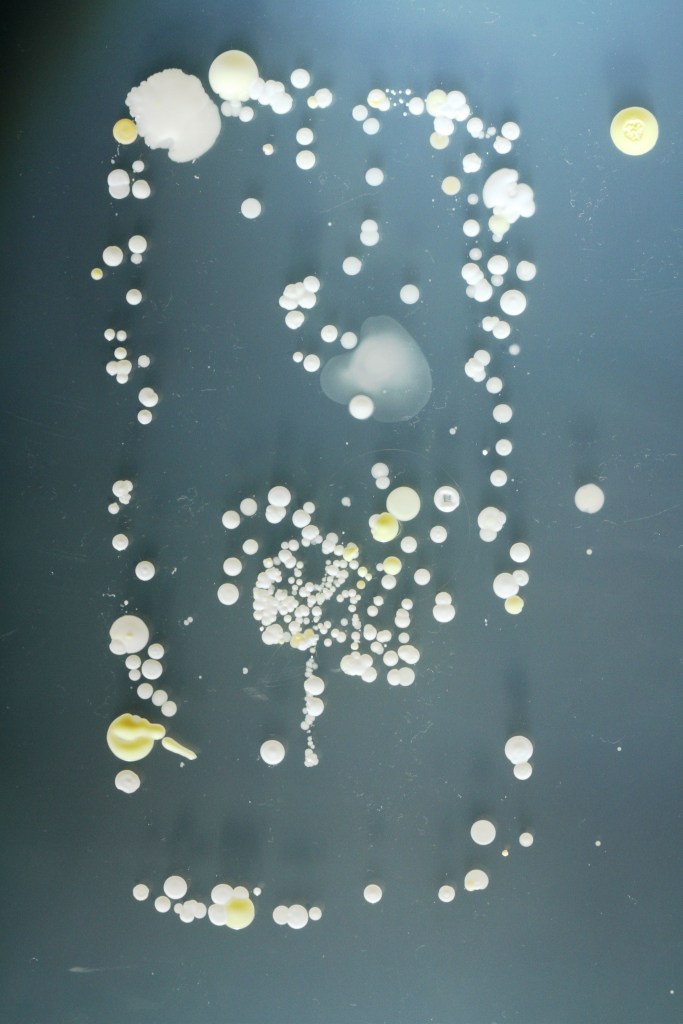

El sitio Explore the invisible publicó un ejercicio llevado a cabo en un curso de Bacteriología Biomédica en la Universidad de Surrey, Inglaterra, donde se les propuso a los alumnos imprimir sus smartphones sobre un soporte de crecimiento bacteriológico para poder determinar lo que podrían llevar.
Explore the invisible nos explica qué es lo que sucede en este experimento: «las bacterias pueden utilizar muchas cosas diferentes como vectores con el fin de fomentar su transmisión. Insectos, el agua, los alimentos, la tos y los estornudos, el contacto sexual y la lluvia son sólo algunos ejemplos. El teléfono móvil parece ser una excepción a esta regla.»
Exploretheinvisible.com conluye: «A partir de estos resultados, parece que el teléfono móvil no sólo recuerda los números de teléfono, pero también alberga una historia de nuestros contactos personales y físicos tales como otras personas, el suelo, etc. 2014.
Todas las imágenes están sujetas a derechos de autor de sus respectivos dueños. Si comparte su trabajo, por favor dales el crédito.
All images are subject to copyright by their respective owners. If you share their work, please give them credit!

[…] Fonte: estoesvortice […]